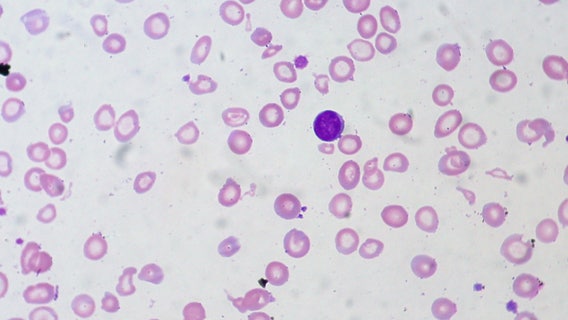
Health experts say ‘harmless’ symptoms could be signs of blood disease

Officials in Mountlake Terrace, WA warn senior citizens of ‘contractor scams’
The City of Mountlake Terrace is warning its neighbors about a contractor scam that is targeting senior citizens.
Senior citizens targeted by contractor scams in Mountlake Terrace
The City of Mountlake Terrace is warning its neighbors about a contractor scam that is targeting senior citizens. City officials said they are working with the police department to investigate at least two reports of a roof repair scheme.
WA sues 'bikini barista' stand owner over sexual harassment, wage theft allegations
The Washington State Attorney General's office is suing the owner of four "bikini barista" coffee stands for allegedly subjecting female employees to sexual harassment, retaliation and wage theft.
First annual 'Wag Fest' in Seattle's Mountlake Terrace
Wag Fest is happening this weekend in Mountlake Terrace and Good Day Seattle is previewing the event.
National Night Out in Mountlake Terrace
It was National Night Out in Mountlake Terrace, an annual event held on the first Tuesday of August to promote police-community partnership.
Health experts say ‘harmless’ symptoms could be signs of blood disease
There is one health condition that affects 1.6 billion people worldwide, but it’s not widely known. Health experts are sounding the alarm over Iron Deficiency Anemia.
Lynnwood Link light rail extension open for commuters
After its grand opening last week, the Lynnwood Link light rail extension is now open for commuters.
‘I miss her voice’: Vigil planned for 13-year-old killed in Alderwood Mall shooting
A vigil is planned Sunday for 13-year-old Jayda Woods-Johnson, an innocent bystander who died after being struck by a stray bullet at the Alderwood Mall.
Free summer meal programs available for WA children, teens
With children and teens home for the summer, several districts throughout the region have set up programs to ensure youth can still receive a free meal during the next couple of months.
DV suspect arrested after SWAT standoff in Mountlake Terrace
A domestic violence suspect was arrested by a SWAT team in Mountlake Terrace early Tuesday morning.
Seattle-area organizations hold weekend Juneteenth events honoring historic holiday
Several Seattle-area organizations held Juneteenth events on Saturday, celebrating and honoring the historical legacy of the federal holiday.
Seattle-area organizations hold weekend Juneteenth events honoring historic holiday
Several Seattle-area organizations held Juneteenth events on Saturday, celebrating and honoring the historical legacy of the federal holiday.
Man shoots through door of Mountlake Terrace apartment, arrested
A man was arrested on Wednesday after allegedly firing multiple shots through the door of a Mountlake Terrace apartment, narrowly missing a woman and her baby.
Mountlake Terrace pot shop heavily damaged
Police are investigating after a pot shop was heavily damaged overnight.
Naturalization ceremony welcomes 31 new U.S. citizens
31 people from 15 different countries became U.S. citizens at the Mountlake Terrace library on Friday.
Lily Gladstone, who grew up in Seattle, becomes first Native American actress nominated for an Oscar
Lily Gladstone knew she wanted to be somewhere special when the Oscar news came. And that somewhere was not home, watching on TV, but in Oklahoma with the Osage community, where the real-life version of her character lived and where Martin Scorsese’s "Killers of the Flower Moon" is centered.
4 armed suspects break into Mountlake Terrace home with family inside, stole car and electronics
Parents and two small children were home at the time when four armed people broke in. Police say there is no known connection between the family and the suspects.
Mountlake Terrace High School evacuated
We are following breaking news, Mountlake Terrace High School was evacuated Wednesday morning due to a mechanical issue.
Thief breaks into North Sound butcher shop, steals safe and gumball machine
After celebrating a day to be thankful, the latest smash-and-grab has a Mountlake Terrace butcher shop picking up the pieces from someone's selfish act.
Police seek help identifying road rage shooting suspect in Mountlake Terrace
Police are asking for the public's help in identifying the suspect in a road rage shooting last Saturday.